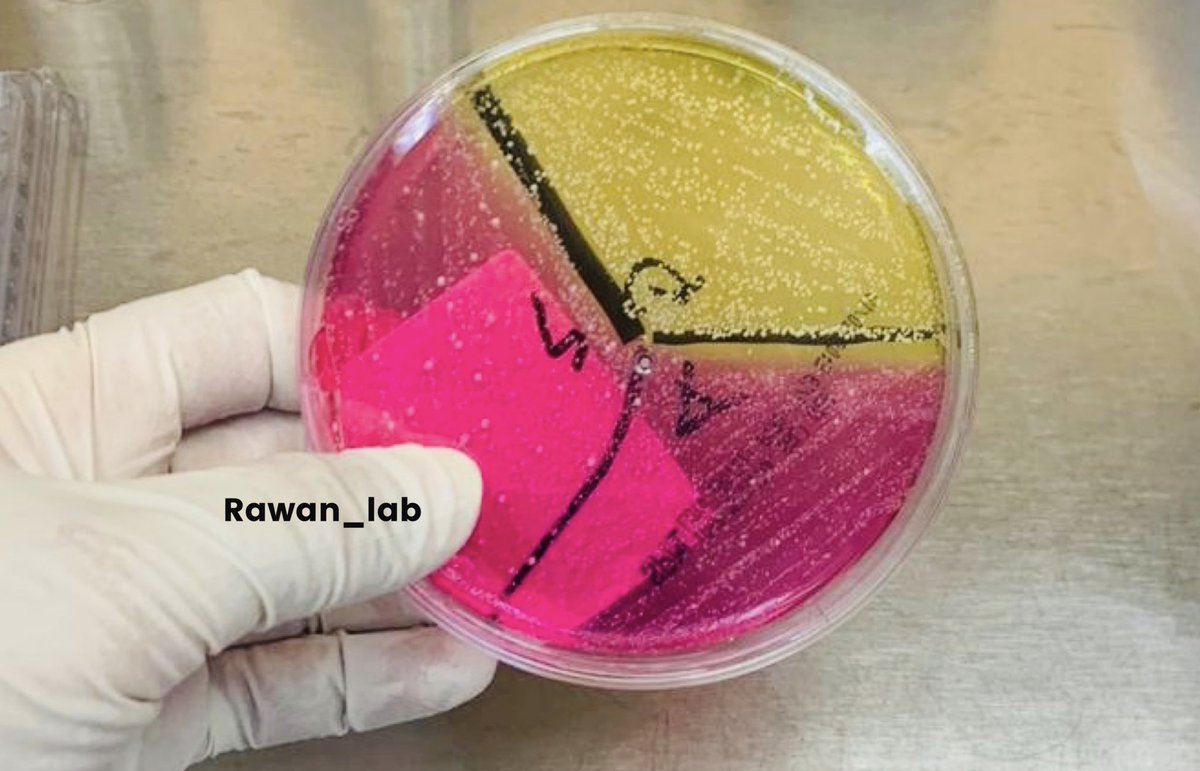
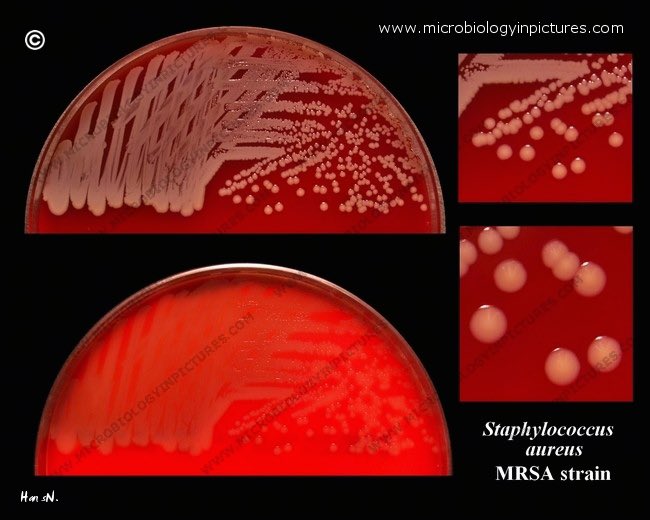

الأعراض🔴
تختلف على حسب المكان المصاب مثلًا اذا كانت على الجلد: swelling, warmth, redness, pain
وطبعًا ما راح نقدر نتأكد انها MRSA الا عن طريق المختبر..
تختلف على حسب المكان المصاب مثلًا اذا كانت على الجلد: swelling, warmth, redness, pain
وطبعًا ما راح نقدر نتأكد انها MRSA الا عن طريق المختبر..
تم بحمد الله?، إن أحسنت فمن الله، وإن أسأت أو أخطأت فمن نفسي والشيطان.
-المراجع الي استعنت فيها:
-CDC cdc.gov
-Lab test online labtestsonline.org
-Lippincott (Microbiology) والكتاب الفنان⬇️✨
-المراجع الي استعنت فيها:
-CDC cdc.gov
-Lab test online labtestsonline.org
-Lippincott (Microbiology) والكتاب الفنان⬇️✨
جاري تحميل الاقتراحات...